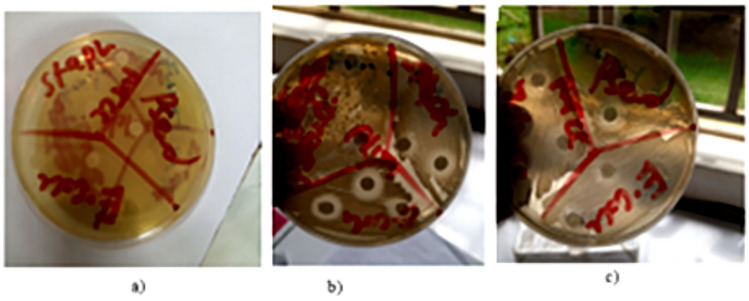

Abstract
Whereas sanitizing wipes are among the strategies for combatting COVID-19, there are growing concerns concerning their disposal, due to majority of them being made of non-biodegradable fibres. Additionally, majority of the sanitizing solutions used are associated with irritations and some are carcinogenic. In this study, banana wipes, impregnated with an organic antimicrobial formulation were developed to counter the unbiodegradable wipes made of synthetic fibres and impregnated with toxic antimicrobial formulations. A spunlaced non-woven fabric made from 100% banana fibres was impregnated with a commercial formulation containing essential oils from lemon, eucalyptus, cedar and orange. The impregnated banana fabric wipe exhibited antimicrobial activity against all tested bacterial strains, including Escherichia coli (both ATCC 25,922 and the wild strain), Staphylococcus aureus (both ATCC 25,923 and the wild strain), and Pseudomonas aeruginosa (both ATCC 27,853 and the wild strain), with inhibition zones ranging from 10.00 ± 1.00 mm to 13.67 ± 1.16 mm, compared to the standard 14.00 mm. Furthermore, the mechanical properties of the fabric showed that the tensile strength in the wet state increased by 4.29% and 20.41% in both the machine and cross directions respectively. Given that synthetic fibres are used in wipes to achieve a high wet tensile strength since most cellulosic fibres become weaker and disintegrate when wet, it can be concluded that banana fibres can be effectively used in wipes application given that they are biodegradable and are stronger when wet.
Keywords: Sanitizing wipes, Banana pseudo-stem, COVID-19, Biodegradability, Bio-based, Nonwoven, Plant extract
Subject terms: Biochemistry, Plant sciences, Health care, Materials science
Introduction
Known methods that have been used to stop the spread of Covid-19 and associated infections include the use of hand washing, hand sanitizers, and immunization. The demand for hand sanitizers peaked when COVID-19 was widespread. In fact, when the epidemic started in December 2019, sanitizers immediately ran out and were in short supply. Despite disinfectants’ success in eradicating COVID-19 and other associated illnesses, concerns have been expressed regarding how their extensive use can impact animals, aquatic environments, and biodiversity. Ingredients like triclosan are linked to carcinogenesis, endocrine disruption, allergies, and antimicrobial resistance1–3. The use of hand sanitizers has also been linked to hormone instability, immune system decline, alcohol poisoning, and exposure to dangerous substances. There have been several instances of unintentional juvenile and adolescent alcohol use all throughout the world4.
Different delivery techniques, such as rubs, foams, or wipes, are used for applying hand sanitizers. While sanitizers are useful, people’s personalities may prevent them from effectively eradicating germs. This is because some people might not use enough hand sanitizer to wipe their hands, which could result in the liquid evaporating before being applied uniformly over the hands. Additionally, the sanitizer might not work on hands that are extremely dirty or chemically contaminated5 Wipes or towelettes are the type of delivery method that some people prefer as a way to guarantee good cleaning due to their mobility, lack of spillage, slow rate of alcohol evaporation, and capacity to distribute alcohol all over the hands6.
Disposable wet tissues are becoming more prevalent in several different goods, including deodorants, moisturizers, suntan lotion, and makeup removal7 Wipes for disinfection are often made from a blend of thermoplastic fibers (polypropylene and polyester) and cellulosic fibers (cotton, lyocell, viscose, and wood pulp). The polyolefin/thermoplastic fibers offer exceptional tensile strength, abrasion resistance, and solvent resistance while the cellulosic fibers offer good water retention8.
The COVID-19 outbreak led to a surge in the production and usage of wet wipes for cleaning, medical and sanitizing purposes. Not only were they applied in cleaning surfaces in hospitals, hotels, restaurants and educational facilities but were also given out as single-pack pieces to flying passengers. To meet the demand around the globe, several wipes’ makers have increased output, which has resulted in an extraordinary increase in Personal Protective clothing waste9.
Due to the wipes’ high synthetic content, they cannot degrade in sludge treatment and wastewater treatment plants. Results, from Water UK conducted between May and October 2017, revealed that baby wipes were the most easily recognized and recovered items from obstructions in pipes and jams in pumps10.
Also, wet wipes made entirely from cellulosic fibres—such as viscose, wood pulp, and cotton—have been found not to biodegrade due to the presence of antimicrobial agents and other chemical additives used to enhance wet strength11.
Therefore, there is an increasing need to investigate possible sources of natural fiber, such as bananas due to the expanding need for biodegradable, environmentally acceptable fiber materials as alternatives to synthetic fiber. Banana fruits (Musa acuminata) are eaten all over the world and are easily accessible in the world’s tropical areas. Banana plantations cover more than 5 million hectares in more than 130 nations. These generate masses of trash from the fruit, including pseudostems that are left to rot and release a lot of methane and carbon dioxide as they decompose12,13 According to Ferdous14, around 1000–1500 pseudo stems may be generated per acre of land on an annual basis. Every hectare of a plantation produces an estimated 220 tonnes of biomass waste annually. As per the FAO report of 2018, there were around 5.72 million hectares of land under cultivation worldwide, producing 1.243 billion tonnes of waste. However, it takes around 10–13 pseudo stems to yield 1—2 kg of banana fiber. Due to their biodegradability, lightweight nature, renewability, and greater biochemical and tensile capabilities, natural fibers of animal and plant origin have undergone extensive research in the past 20 years and are increasingly obtaining prominence over synthetic alternatives15 Additionally, there is current research into producing sanitary napkins from banana fibers16,17.
The development of wet wipes from 100% natural fibres has a potential of offering solutions to banana waste while at the same time reducing the environmental footprint of synthetic fibres. Furthermore, it is highly praiseworthy to replace harmful chemical compounds and synthetic scents in sanitizer compositions with natural and sustainable substances. From the surveyed literature, there is no known attempt to study banana fibers for wet wipe applications. This study is aimed at producing 100% natural hand wipes from banana fibers and impregnate them with a natural antimicrobial formulation.
Experiments
Materials
A commercial lemon sanitizer containing majorly essential oils from lemon and additional oils from eucalyptus, cedar and orange was purchased from Prof Bioresearch, Uganda. The formulation also contained floral water and hydrosols. A wipe fabric made from 100% banana fibres was provided by Shanghai Uneed Textile Co., Ltd (UNT), China. The wipe was produced by spunlace technology, also known as hydroentangling. Mueller Hinton agar, bacterial strains including Escherichia coli (E. coli) (ATCC 25,922), E. coli (wild), Staphlococcus aureus (S. aureus) (ATCC 25,923), S. aureus (wild), Pseudomonas aeruginosa (ATCC 27,853) and P. aeruginosa (wild) were obtained from Mbale Clinical Research Institute (Mbale, Uganda). 100% Polysorbate 20 was purchased from Sky Chem (U) Limited (Kampala, Uganda).
Fourier Transform Infra-Red (FTIR) spectroscopy of spunlaced wipe
The FTIR analysis was carried out on the fabric sample and untreated banana fibres to ascertain whether it was made from banana fibres. The Fourier Transform Infra-Red (FTIR) Spectrometer (FT/IR-6600 type A, JASCO International Co., Ltd., Japan) was used to determine the chemical functional groups in the fibres. Ranges of 400 ~ 4000 cm−1 and a resolution of 4 cm−1 were used for scanning.
Mechanical and physical properties of the wipe fabric
Dry and wet tensile properties
The dry and wet tensile properties (in both machine and cross directions) of the fabric were measured with a tensile tester (Unistretch 500, MAG- G0152, Serial No. 2117010323 of MAG Solvics Private Limited, Coimbatore, India). The tests were carried out in accordance with ISO 9073–18 Grab tensile strength. Tensile tests were conducted on rectangular samples (100 mm × 150 mm), the length between clamps was taken at 75 mm, and the test speed was set at 300 mm/min. Samples were tested and the average values for the dry tensile strength, wet tensile strength and elongation were calculated. The tests were done in triplicate.
In calculating the wet tensile strength, the cut samples of 100 mm × 150 mm, were pre-wetted with tap water by immersing them for 1 h to allow complete saturation and mimic wet wipes. After removing the samples from water, they were gently pressed until a wet pick-up percentage of 300% was achieved, following the calculation in Eq. 1 below:
 |
1 |
where  is the mass of the squeezed wet wipe (g) and
is the mass of the squeezed wet wipe (g) and  is the mass of the dry wipe (g).
is the mass of the dry wipe (g).
After removing the excess water, samples were tested within 1 min.
Bursting strength
Bursting strength was measured using a bursting strength tester (DigiBurst, MAG-C0651, Serial No.: 9251624044 of MAG Solvics Private Limited, Coimbatore, India). The tests were carried out in accordance with ISO 2758. The test was done in triplicate.
Mass per unit area
The samples were tested in accordance with ISO 9073–1. A circular cutter (Circucut, MAG-C0111, Serial No.: 2124004049 of MAG Solvics Private Limited, Coimbatore, India). A surface area of 100 cm2 was cut for all sample to determine the mass per unit area. The test was done in triplicate.
Thickness
Thickness of the fabric was measured using a thickness gauge tester at a pressure of 4.14 kPa (Anathick, MAG-C1001, Serial No.: 2135055091 of MAG Solvics Private Limited, Coimbatore, India). The tests were carried out in accordance with ISO 1765. Ten readings were taken at different places of the specimen and the mean and the standard deviation were calculated.
Air permeability
Air permeability of the fabric was measured using an air permeability tester (MAG- C2855, Serial No.: 2150005014 of MAG Solvics Private Limited, Coimbatore, India). The tests were carried out in accordance with ISO 9237:1995. Ten readings were taken at different places of the specimen and the mean and the standard deviation were calculated.
Antimicrobial properties of wipe fabrics
The wipe was impregnated with a commercial lemon oil formulation obtained from Prof Bioresearch, used at 100% concentration. This was justified by the fact that the formulation was already pre-blended with complementary ingredients, including floral water, making it suitable for direct application without further dilution. According to the manufacturer’s label, the commercial formulation, known as Prof Lemon Sanitizer, contained multiple functional ingredients, including lemon essential oil, eucalyptus essential oil, cedar essential oil, orange essential oil, hydrosols and floral water. The shelf life of the lemon sanitizer, was indicated as 2 years. To facilitate complete miscibility of the formulation, a concentration of 0.2% Polysorbate 20 (Tween-20) was added to the commercial formulation. A concentration of 2% was selected basing on a study in which 2% is sufficient to achieve an emulsification effect for botanical extracts18. The efficacy of the impregnated wipe to remove and eliminate E. coli (ATCC 25,922), E. coli (wild), S. aureus (ATCC 25,923), S. aureus (wild), P aeruginosa (ATCC 27,853) and P. aeruginosa (wild) was investigated.
The banana fabric material was cut into 6 mm2 and autoclaved in a hot air oven at 160 0C for 1 h, to make the material sterile. After sterilization, the samples were placed on a petri-dish and the antimicrobial formulation was poured on the material, until they were full immersed, and allowed to settle for 10 min so that the wipes could absorb the solution. Following soaking, samples were gently pressed to remove excess formulation and placed on Agar plates, containing the bacterial strains. The Agar plates were incubated at 37 0C for 24 h. Zones of inhibition were read with the aid of an inhibition zone ruler (Bioanalyse, Turkey). The diameters of the zones of inhibition were measured in mm. Triplicate tests were carried out in all experiments.
Descriptive statistics
The mean and variance of data in this study were analyzed using the Minitab program version 17.
Packaging
The banana fabric material was cut into pieces of length 100 mm and width 50 mm and autoclaved in a hot air oven at 160 0C for 1 h, to make the material sterile. After sterilization, the samples were placed in a beaker containing the antimicrobial formulation. They were fully immersed and allowed to settle for 10 min so that the wipes could absorb the solution. Following soaking, samples were gently pressed to remove excess formulation and sealed in polyethylene materials with the help of an impulse sealer electric plastic bag heat machine (PFS-100, Zhejiang Tianyu industry Co. Ltd, China). Figure 1 shows the steps that were followed in packaging the wet wipe samples.
Fig. 1.
Packaging of wipes.
Results and discussions
Fourier transform Infra-red (FTIR) analysis of the spunlaced non-woven fabric made from banana fibres
Figure 2 shows the FTIR scans that were in the range of 400–4000 cm-1 and a resolution of 4 cm-1.
Fig. 2.

Spectra of a) Banana raw fibre and b) spun-lace non-woven fabric made from banana fibres.
As observed, there is a C-H stretching vibration at 893 cm−1 which signifies the presence of cellulose and hemicellulose, a sharp C-O stretching at 1030 cm−1 signifying the presence of alcohol in cellulose, lignin and hemicellulose, many C = O stretching vibrations between 1239 and 1403 cm−1 which signify the presence of lignin, a stretching band around 1644 cm−1 which signifies C = C and presence of lignin, a band at 1736 cm−1 which signified C = O and presence of lignin and hemicellulose. At 2352, detection of bending alkyne C≡C. At 2905 cm−1, there is the stretching C-H which signifies the presence of hemicellulose and finally between 3200–3500 cm−1, the presence of O–H group which signifies presence of cellulose, hemicellulose and lignin19,20.
From the spectra of both the raw banana fibre and the spun-laced fabric, it can be concluded that the spun-laced non-woven fabric was made from banana fibres. This is because of the similarity in the peaks.
Antimicrobial efficacy of a wet wipe treated with antimicrobial formulation
Sensitivity of different bacterial strains to the impregnated wipes was measured in terms of zone of inhibition using agar diffusion assay. The results are presented in Table 1 and summarized in a box-plot in Fig. 3. The layout of this experiment on an agar plate is shown in Fig. 4.
Table 1.
Inhibitory activity of impregnated banana fabric.
| Bacteria | Zone of inhibition (mm) | Standard |
|---|---|---|
| E. Coli (ATCC) | 11.00 ± 1.73 | 14.00 |
| E. Coli (Wild) | 13.67 ± 1.16 | 14.00 |
| S. aureus (ATCC) | 10.67 ± 0.58 | 14.00 |
| S. aureus (Wild) | 10.00 ± 1.00 | 14.00 |
| P. aeruginosa (ATCC) | 11.33 ± 0.58 | 14.00 |
| P. aeruginosa (Wild) | 11.33 ± 0.58 | 14.00 |
Fig. 3.
Image showing a) the agar plate before incubation b) Inhibitory activity against S. aureus (wild), P. aeruginosa (wild), E.coli (wild) c) Inhibitory activity against S. aureus (ATCC 25,923), P. aeruginosa (ATCC 27,853), E.coli (ATCC 25,922).
Fig. 4.

Box plot showing inhibitory activity of impregnated fabric against bacteria.
The maximum zone of inhibition was observed against E. coli (wild) with a mean of 13.67 mm of inhibition. From previous research, lemon oils have been found to be effective against microbial organisms21. The inhibition zones falling just below the 14 mm benchmark could be attributed to several factors, including the type of microorganism—since some strains exhibit higher resistance—the concentration of the essential oil, suboptimal diffusion of active compounds in the agar medium, and inadequate solubilization or distribution of the active ingredients22. Whereas the antibacterial potential of a banana-fibre based fabric, impregnated with an.
antimicrobial formulation is being studied for the first time, the results show that lemon oil maintains its efficacy.
Mechanical and physical properties of the spunlaced non-woven wipe
The spunlaced non-woven wipe performed as indicated in Table 2. Figure 5 gives a comparison of the dry and wet tensile strength. Figure 6 gives a comparison of the elongation in the wet and dry state.
Table 2.
Wipe mechanical and physical properties.
| Parameter | Mean value ± Standard deviation |
|---|---|
| Tensile strength, Machine Direction (MD) (dry), N | 159.848 ± 4.903 |
| Tensile strength, Cross Direction (CD) (dry), N | 110.488 ± 9.423 |
| Tensile strength, MD (wet), N | 166.712 ± 1.961 |
| Tensile strength, CD (wet), N | 133.043 ± 5.177 |
| Elongation at break, MD (dry), % | 32.000 ± 3.755 |
| Elongation at break, CD (dry), % | 51.244 ± 5.751 |
| Elongation at break, MD (wet), % | 23.689 ± 0.505 |
| Elongation at break, CD (wet), % | 33.111 ± 0.658 |
| Bursting strength, kPa | 460.7 ± 31.3 |
| Mass per unit area, g/m2 | 50.67 ± 4.04 |
| Thickness, mm | 0.383 ± 0.028 |
| Air permeability, cc/s/cm | 177.8 ± 27.8 |
Fig. 5.

Box-plot of tensile strength, (N).
Fig. 6.

Box plot of elongation, (%).
The tensile strength in the wet state was higher in comparison with that in the dry state in both machine and cross directions. The tensile strength of the wet samples in the machine and cross directions was.
about 4.29% and 20.41% higher respectively. It is known that most of the cellulosic fibres show reduced tensile strength due to the breakage of hydrogen bonds23. Therefore, moisture uptake by the banana fibres likely caused fibre swelling, which enhanced intermolecular hydrogen bonding and consequently led to an increase in tensile strength.
The elongation at break of the fabrics in the wet state was lower in both the machine and cross directions.
As observed in Table 2, Figs. 5 and 6, the wipes were found to have higher tensile strength and lower elongation values when wet. This is contrary to the general experience for wet wipes in daily use. It is known that manufacturing decomposable wet wipes with sufficient wet strength to meet daily use is challenging. This is because in the wet state, interactions between the cellulose fibres, namely van der Waals forces and H-bonding, are severely weakened resulting in a dramatic decrease of mechanical strength of the material5.
In addition, the obtained values of a mass per unit area of 50 g/m2 and tensile strength of 166.712 N and 133.043 N for the machine and cross directions respectively comply with the requirements specified in EAS 1075: 2022, Disposable wet wipes — Specification. This particular standard requires a minimum of 36 g/m2 and 5 N and 4 N for the wet tensile strength in both the machine and cross directions respectively.
The results of this study offer promising results. In comparison with results obtained in the study carried out by Cheriaa & Boubaker24, on typical baby wipes, the wet wipes, being considered, in this study performed better. The wet tensile index (obtained using the Eq. 2) of 8.59 N.m.kg−1 in the machine direction was better than 3.48 N.m.kg−1 and 2.27 N.m.kg−1 for the baby wipes that were under study. Similarly, the wet tensile index of 6.86 N.m.kg−1 in the cross direction was far better than 0.655 N.m.kg−1 and 0.507 N.m.kg−1 in the baby wipes.
 |
2 |
With such a performance, it can be concluded that banana fibres have excellent wet tensile strength that is sufficient for wipes’ application.
Conclusions
In this study, banana wipes, impregnated with an organic antimicrobial formulation, were developed to counter the unbiodegradable wipes made of synthetic fibres and impregnated with toxic antimicrobial formulations. A spunlaced non-woven fabric made from 100% banana fibres was impregnated with a commercial formulation containing essential oils from lemon, eucalyptus, cedar and orange. The antimicrobial efficacy test done on the impregnated wipe showed inhibitory activity against all the bacterial strains. Furthermore, the mechanical properties of the fabric showed that the tensile strength in the wet state increased by 4.29% and 20.41% in both the machine and cross directions respectively. Given that synthetic fibres are used in wipes to achieve a high wet tensile strength since most cellulosics become weaker and disintegrate when wet, it can be concluded that banana fibres can be effectively used in wipes functionality given that they are biodegradable and are stronger when wet.
Banana fibre wipes show promising commercial potential, leveraging locally available raw materials and cost-effective processing. They offer a biodegradable alternative to conventional synthetic wipes, though further economic analysis and pilot-scale studies are needed to confirm large-scale feasibility.
Limitations of the study
The study was limited by the absence of both negative controls (untreated banana wipes) and positive controls (commercial synthetic wipes), which are essential for benchmarking antimicrobial efficacy. Future studies should incorporate these controls to enable more robust validation and comparison of antimicrobial performance. In addition, further research is needed to evaluate the dispersibility behavior of banana fibre-based wipes and to monitor potential microbial growth during storage, in order to assess the product’s preservation stability.
In addition, this study did not include short-term stability assessments, such as antimicrobial activity or physical integrity after storage. This is acknowledged as a limitation, and we recommend that future work incorporate stability testing under real or simulated storage conditions to better evaluate the practical performance and shelf-life of the product.
Acknowledgements
The authors acknowledge Prof Bioresearch Uganda for providing a commercial formulation containing essential oils from lemon, eucalyptus, cedar and orange; the Natural Products Research & Innovation Centre, Mbale and Uganda Industrial Research Institute for providing equipment for carrying out antibacterial and mechanical tests; the Materials and Metallurgy laboratory, and the Textile laboratory of Busitema University for materials characterization support. Mr. Godias Tumusiime for experimental support, Mr. Kimani Muturi and TEXFAD Uganda for providing banana fibers and conceptual support.
Author contributions
M. A. Did Conceptualization, Formal Analysis, Resources, Supervision, Data analysis, Writing-First Draft K. L. Brian. Did Conceptualization, Investigation, Methodology, Graphical, Writing First Draft, Revision K. E. Conceptualization, Resources, Funding Acquisition, Project Management, Writing Revised Draft.
Funding
This research was partly supported by the Uganda National Council for Science and Technology (UNCST), and the Sustainable Manufacturing and Environmental Pollution Programme (SMEP) of the FCDO, UK.
Data availability
The authors declare that the data supporting the findings of this study are available within the paper. Should any other raw data files be needed in another format, they will be availed from the corresponding author upon reasonable request."Data will be made available upon request from corresponding author".
Declarations
Competing interests
The authors declare no competing interests.
Footnotes
Publisher’s note
Springer Nature remains neutral with regard to jurisdictional claims in published maps and institutional affiliations.
References
- 1.Donaghy, J. A. et al. Relationship of sanitizers, disinfectants, and cleaning agents with antimicrobial resistance. J. Food Prot.82(5), 889–902. 10.4315/0362-028X.JFP-18-373 (2019). [DOI] [PubMed] [Google Scholar]
- 2.Jahromi, R., Mogharab, V., Jahromi, H. & Avazpour, A. Synergistic effects of anionic surfactants on coronavirus (SARS-CoV-2) virucidal efficiency of sanitizing fluids to fight COVID-19. Food Chem. Toxicol.145, 111702. 10.1016/j.fct.2020.111702 (2020). [DOI] [PMC free article] [PubMed] [Google Scholar]
- 3.Wang, M. et al. Enhanced hand-to-mouth exposure from hand sanitizers during the COVID-19 pandemic: A case study of triclosan. Sci. Bull.67(10), 995–998. 10.1016/j.scib.2022.03.016 (2022). [DOI] [PubMed] [Google Scholar]
- 4.Marumure, J., Makuvara, Z., Alufasi, R., Chapungu, L. & Gufe, C. Effectiveness of hand sanitizers in the prevention of COVID-19 and related public health concerns: A review. Cogent Pub. Health10.1080/27707571.2022.2060904 (2022). [Google Scholar]
- 5.Yun, T. et al. Balancing the decomposable behavior and wet tensile mechanical property of cellulose-based wet wipe substrates by the aqueous adhesive. Int. J. Biol. Macromol.164, 1898–1907. 10.1016/j.ijbiomac.2020.08.082 (2020). [DOI] [PMC free article] [PubMed] [Google Scholar]
- 6.Abuga, K. & Nyamweya, N. Alcohol-based hand sanitizers in COVID-19 prevention: A multidimensional perspective. Pharmacy9(1), 64. 10.3390/pharmacy9010064 (2021). [DOI] [PMC free article] [PubMed] [Google Scholar]
- 7.Celeiro, M., Lamas, J. P., Garcia-Jares, C. & Llompart, M. Pressurized liquid extraction-gas chromatography-mass spectrometry analysis of fragrance allergens, musks, phthalates and preservatives in baby wipes. J. Chromatogr. A1384, 9–21. 10.1016/j.chroma.2015.01.049 (2015). [DOI] [PubMed] [Google Scholar]
- 8.Song, X., Vossebein, L. & Zille, A. A. Efficacy of disinfectant-impregnated wipes used for surface disinfection in hospitals: A review. Antimicrobial Resistance and Infection Control. BioMed. Central Ltd.10.1186/s13756-019-0595-2 (2019). [DOI] [PMC free article] [PubMed] [Google Scholar]
- 9.Shruti, V. C., Pérez-Guevara, F. & Kutralam-Muniasamy, G. Wet wipes contribution to microfiber contamination under COVID-19 era: An important but overlooked problem (Elsevier B.V, 2021). 10.1016/j.envc.2021.100267. [DOI] [PMC free article] [PubMed] [Google Scholar]
- 10.Atasağun, H. G. & Bhat, G. S. Advancement in flushable wipes: Modern technologies and characterization. J. Ind. Text. SAGE Publ. Ltd.49(6), 722–747. 10.1177/1528083718795910 (2020). [Google Scholar]
- 11.Dinu, L. D., Lordache, O. & Vamanu, E. Scanning electron microscopy study on the biodeterioration of natural fiber materials compared to disposable hygiene and sanitary products. Fermentation8(6), 287. 10.3390/fermentation8060287 (2022). [Google Scholar]
- 12.Priyadarshana, R. W., Kaliyadasa, P. E., Ranawana, S. R. & Senarathna, K. G. Biowaste management: Banana fiber utilization for product development. J. Nat. Fibers Taylor Francis Ltd10.1080/15440478.2020.1776665 (2022). [Google Scholar]
- 13.Kumaresan M, Ramesh N, Ramesh S, Vijay Benjamin Lazarus S. Review on mechanical behavior of sisal & banana fibre reinforced polymer composites. Int J Adv Manage Technol Eng Sci. (Vol. 2, Issue 1). https://www.academia.edu/download/51877882/6.IJARMET-2017-02-01-05.pdf (2017)
- 14.Ferdous, T. et al. Pulping and bleaching potential of banana pseudo stem, banana leaf and banana peduncle. Biomass Convers. Biorefin.10.1007/s13399-020-01219-6 (2021). [Google Scholar]
- 15.Balda, S., Sharma, A., Capalash, N. & Sharma, P. Banana fibre: A natural and sustainable bioresource for eco-friendly applications Springer Science and Business Media Deutschland GmbH. Clean Technol. Environ. Policy10.1007/s10098-021-02041-y (2021). [Google Scholar]
- 16.Mohiuddin, A. K., Saha, M. K., Hossian, M. S. & Ferdoushi, A. Usefulness of banana (Musa paradisiaca) wastes in manufacturing of bio-products: A review. Agriculturists12(1), 148–158. 10.3329/agric.v12i1.19870 (2014). [Google Scholar]
- 17.Rajput, A. & Khot, A. Functional aspect of eco-friendly banana fibre as textile. Int. J. Home Sci.10.22271/23957476.2022.v8.i3a.1341 (2022). [Google Scholar]
- 18.Hsiao, F. S. et al. Optimization of emulsification conditions on ethanol extract of Taiwanese green propolis using polysorbate and its immunomodulatory effects in broilers. Animals12(4), 446. 10.3390/ani12040446 (2022). [DOI] [PMC free article] [PubMed] [Google Scholar]
- 19.Hospodarova, V., Singovszka, E. & Stevulova, N. Characterization of cellulosic fibers by FTIR spectroscopy for their further implementation to building materials. Am. J. Anal. Chem.09(06), 303–310. 10.4236/ajac.2018.96023 (2018). [Google Scholar]
- 20.Twebaze, C. et al. Banana fiber degumming by alkali treatment and ultrasonic methods. J. Nat. Fibers19(16), 12911–12923. 10.1080/15440478.2022.2079581 (2022). [Google Scholar]
- 21.Valeriano, C. et al. The sanitizing action of essential oil-based solutions against Salmonella enterica serotype Enteritidis S64 biofilm formation on AISI 304 stainless steel. Food Control10.1016/j.foodcont.2011.12.015 (2012). [Google Scholar]
- 22.Evrendilek, G. A. Empirical prediction and validation of antibacterial inhibitory effects of various plant essential oils on common pathogenic bacteria. Int. J. Food Microbiol.202(35–41), 0168–1605. 10.1016/j.ijfoodmicro.2015.02.030 (2015). [DOI] [PubMed] [Google Scholar]
- 23.Binu Kumar, V. J., Bensam Raj, J., Karuppasamy, R. & Thanigaivelan, R. Influence of chemical treatment and moisture absorption on tensile behavior of neem/banana fibers reinforced hybrid composites: An experimental investigation. J. Nat. Fibers19(8), 3051–3062. 10.1080/15440478.2020.1838995 (2022). [Google Scholar]
- 24.Cheriaa, R. & Boubaker, J. Quality assessment of baby wet wipes. J. Ind. Text.10.1177/15280837211046619 (2022). [Google Scholar]
Associated Data
This section collects any data citations, data availability statements, or supplementary materials included in this article.
Data Availability Statement
The authors declare that the data supporting the findings of this study are available within the paper. Should any other raw data files be needed in another format, they will be availed from the corresponding author upon reasonable request."Data will be made available upon request from corresponding author".